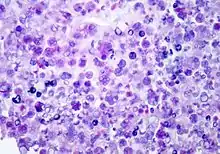

| Prototheca wickerhamii | |
|---|---|
![]() | |
| Scientific classification | |
| (unranked): | Viridiplantae |
| Division: | Chlorophyta |
| Class: | Trebouxiophyceae |
| Order: | Chlorellales |
| Family: | Chlorellaceae |
| Genus: | Prototheca |
| Species: | P. wickerhamii |
| Binomial name | |
| Prototheca wickerhamii K.Tubaki & M.Soneda | |
Prototheca wickerhamii is a ubiquitous green alga that does not have chlorophyll. It is widely present in the environment but is a rare cause of opportunistic infection in humans (protothecosis).
Biology
P. wickerhamii has a round to elliptical cell shape measuring 3–11 µm in diameter. The organism has thick wall (theca) with internal septations that form the small wedge-shaped endospores, which are arranged radially and moulded (morula-like form).[1]. Reproduction is asexual by release of the spores from the sporangia, which can occur every 5-6 hours in ideal conditions.[2]
P. wickerhamii can be found ubiquitously in the environment as Prototheca species have been found associated with plants, fresh and sea water as well as the soil. P. wickerhamii can be cultured on Sabouraud dextrose agar.
Infection
P. wickerhamii can cause opportunistic infections, commonly in individuals with a suppressed immune system due to disease or medication. It is the primary cause of protothecosis in humans. Infection usually results by direct traumatic inoculation[1] and most commonly presents as nodules of the skin.[3]
Diagnosis can be made through culture of diseased tissue in Sabouraud dextrose agar or by visualization of sporangia containing sporangiospores on tissue biopsy (using hematoxylin/eosin, GMS, or PAS histochemical stains). The organism incites a chronic granulomatous inflammation with infiltrate of histiocytes, lymphocytes, giant cells and occasional eosinophils.
Differential diagnosis: Protothecal sporangia may be confused with Coccidioides immitis, which are much larger
Antimicrobial therapy
There is currently no standardized for infection with P. wickerhamii. Positive results of treatment with Voriconazole[4] have been reported as well as with amphotericin B.[5] Strains have also showed susceptibility to further azole compounds such as itraconazole and posaconazole.[3]
References
- 1 2 John R. Goldblum (ed.). Foundations in diagnostic pathology.
{{cite book}}: Missing or empty|title=(help) - ↑ Lass-Flörl C, Mayr A. Human protothecosis. Clin Microbiol Rev. 2007 Apr;20(2):230-42. Review. PMID 17428884
- 1 2 Curbelo A & Pankey GA (2009). "A man presenting with nodules on hands and elbows". Clin Infect Dis. 48 (8): 1160–1161. doi:10.1086/597466. PMID 19292636.
- ↑ Linares, Maria José; Solís, Francisco; Casal, Manuel (2005). "In vitro activity of voriconazole against Prototheca wickerhamii: comparative evaluation of sensititre and NCCLS M27-A2 methods of detection". Journal of clinical microbiology. 43 (5): 2520–2522. doi:10.1128/JCM.43.5.2520-2522.2005. PMC 1153790. PMID 15872301.
- ↑ Mohabeer, A. J.; Kaplan, P. J.; Southern Jr, P. M.; Gander, R. M. (1997). "Algaemia due to Prototheca wickerhamii in a patient with myasthenia gravis". Journal of Clinical Microbiology. 35 (12): 3305–3307. PMC 230169. PMID 9399541.